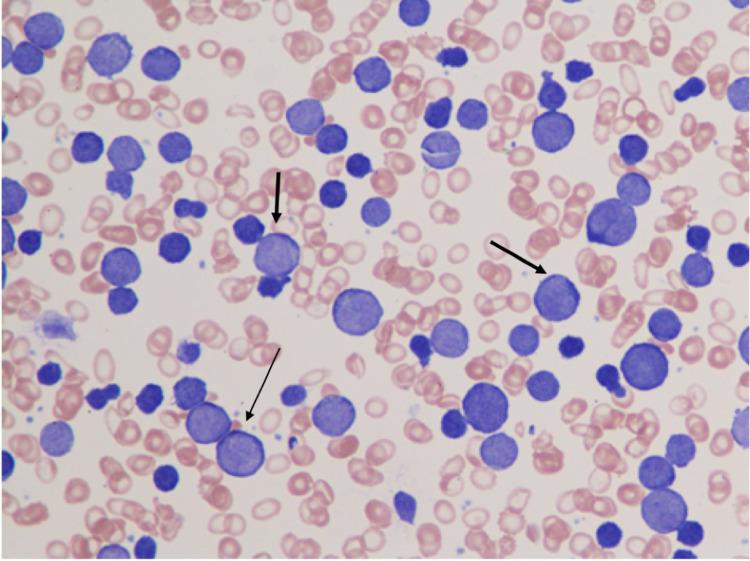
https://cdn.ncbi.nlm.nih.gov/pmc/blobs/dc13/8301267/46da3955d1d8/cureus-0013-00000015838-i01.jpg

伴有白血病转化的CD5+弥漫性大B细胞淋巴瘤:1例累及中枢神经系统的罕见病例,采用R-CHOP方案及鞘内注射甲氨蝶呤/阿糖胞苷治疗
CD5+ Diffuse Large B-Cell Lymphoma With Leukemic Transformation: A Rare Case With Central Nervous System Involvement, Treated With R-CHOP and Intrathecal Methotrexate/Cytarabine.
作者信息
Cordova Justin, Nelson Blessie, Brizendine Ashley M, Iqbal Fatima, Venkatesan Rohit
机构信息
Department of Hematology and Oncology, University of Texas Medical Branch, Galveston, USA.
Department of Pathology and Laboratory Medicine, University of Texas Medical Branch, Galveston, USA.
出版信息
Cureus. 2021 Jun 22;13(6):e15838. doi: 10.7759/cureus.15838. eCollection 2021 Jun.
Diffuse large B-cell lymphoma (DLBCL) is one of several subtypes of non-Hodgkin's lymphoma, and one that can present in a myriad of ways. One unique and particularly aggressive presentation is leukemic transformation with CD5 positivity, which leads to systemic symptoms, a relatively high peripheral tumor load, and higher rates of CNS involvement. The prevalence of leukemic transformation has not been determined, as published literature is limited to case reports and small case series. CD5 positivity appears to be even rarer and is only found in a small fraction of DLBCL with leukemic transformation. Treatment regimens for this presentation have not been well-established due to the rarity of the disease and paucity of literature on the subject. Our patient, a 76-year-old female with a history of previously treated stage IIIB follicular lymphoma, was found to have CD5+ DLBCL with leukemic transformation. She was treated with rituximab, cyclophosphamide, doxorubicin, vincristine, and prednisone (R-CHOP) along with intrathecal methotrexate (IT MTX)/cytarabine after CNS involvement was diagnosed. The patient tolerated therapy well, with an objective reduction in leukocytosis and blast count. To our knowledge, this is the first such case of CD5+ DLBCL with leukemic transformation treated with dose-reduced R-CHOP and IT MTX/cytarabine. Her response to therapy indicates that this regimen could be a viable option for the treatment of this exceedingly rare disease presentation.
弥漫性大B细胞淋巴瘤(DLBCL)是非霍奇金淋巴瘤的几种亚型之一,其表现形式多种多样。一种独特且特别侵袭性的表现是伴有CD5阳性的白血病转化,这会导致全身症状、外周肿瘤负荷相对较高以及中枢神经系统受累率较高。由于已发表的文献仅限于病例报告和小病例系列,白血病转化的患病率尚未确定。CD5阳性似乎更为罕见,仅在一小部分发生白血病转化的DLBCL中发现。由于该疾病罕见且关于该主题的文献匮乏,针对这种表现的治疗方案尚未确立。我们的患者是一名76岁女性,有先前治疗过的IIIB期滤泡性淋巴瘤病史,被发现患有伴有白血病转化的CD5 + DLBCL。在诊断出中枢神经系统受累后,她接受了利妥昔单抗、环磷酰胺、阿霉素、长春新碱和泼尼松(R-CHOP)治疗以及鞘内注射甲氨蝶呤(IT MTX)/阿糖胞苷。患者对治疗耐受性良好,白细胞增多症和原始细胞计数客观上有所降低。据我们所知,这是首例用剂量减少的R-CHOP和IT MTX/阿糖胞苷治疗的伴有白血病转化的CD5 + DLBCL病例。她对治疗的反应表明,该方案可能是治疗这种极其罕见疾病表现的可行选择。